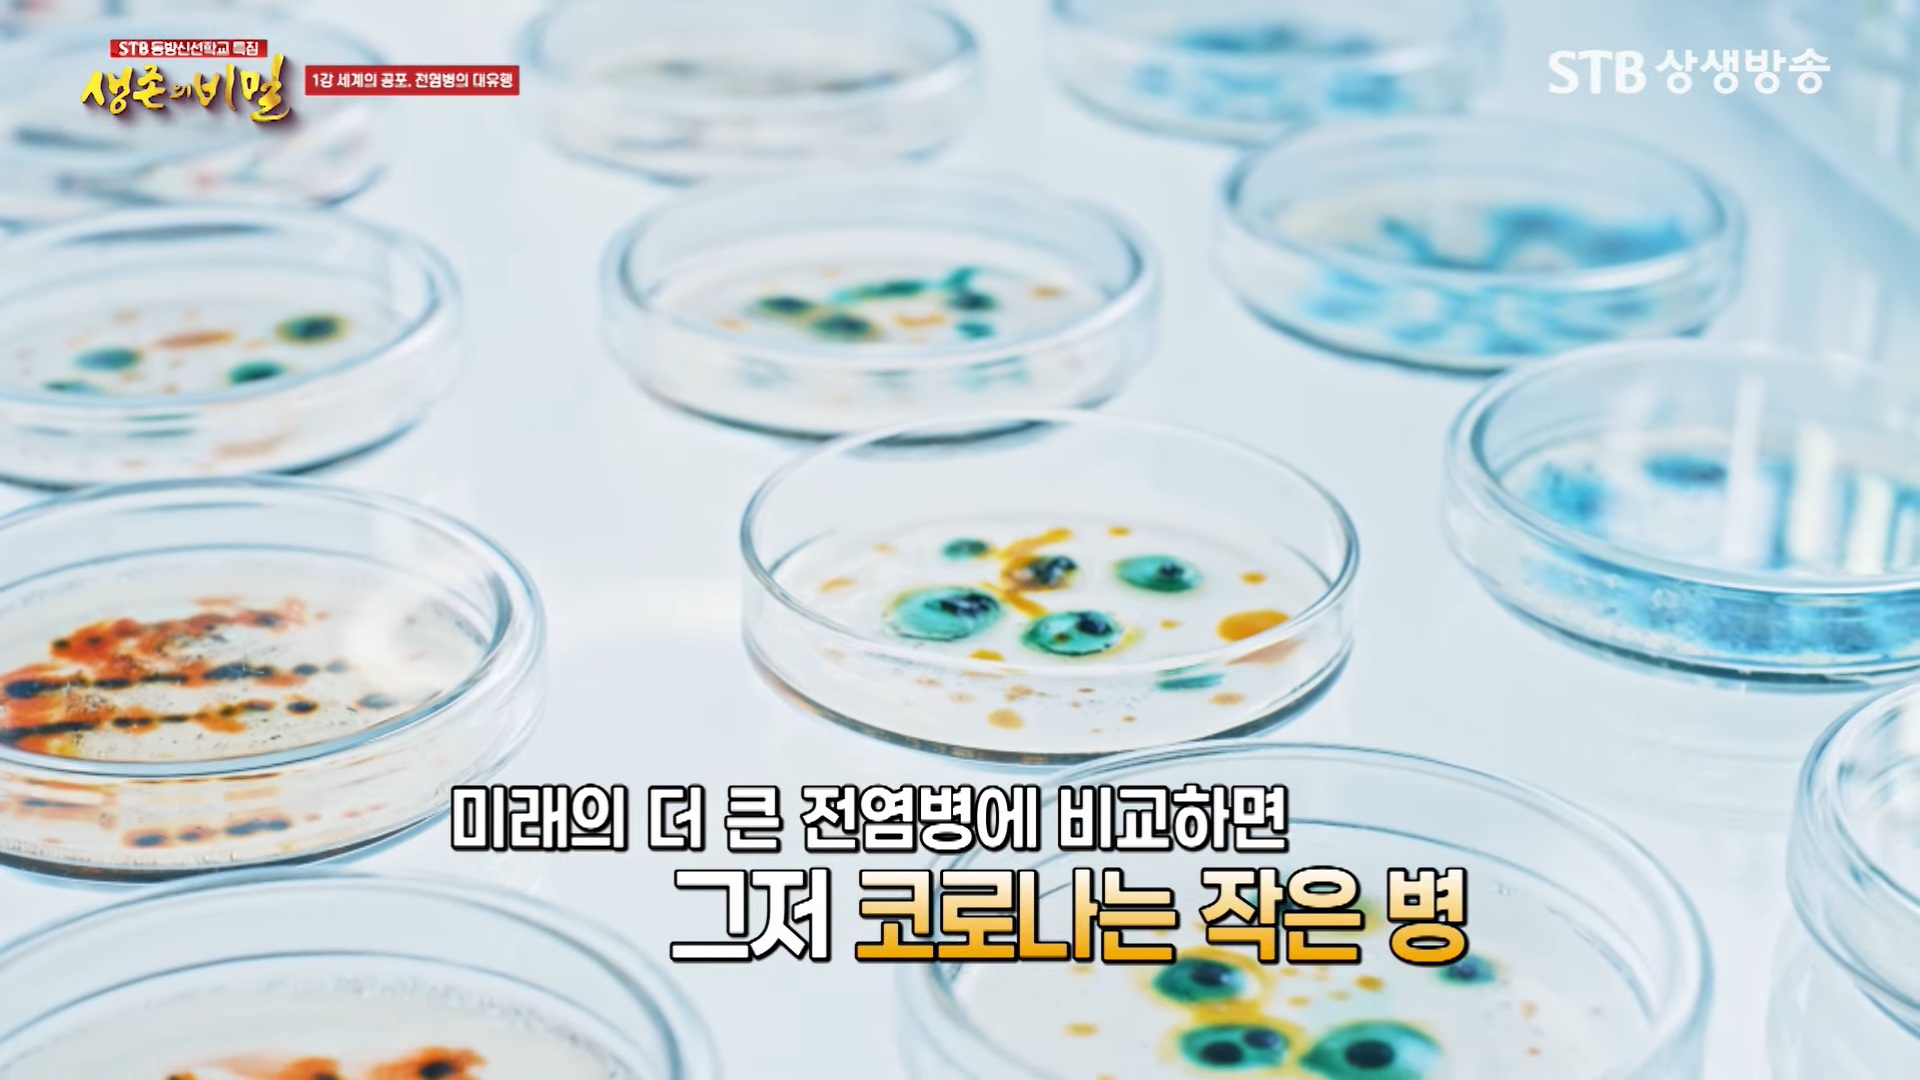

《증산도 동방신선학교》 <생존의 비밀 1강>
병란(病亂)시대 진입의 신호탄 코로나19 감염병 팬데믹
머지않아 지구촌 전역을 휩쓸 전염병 세계적 대유행




아직도 살아 꿈틀거리는 코로나19 바이러스, 사람에게 전파되는 조류 인플루엔자 바이러스, 폴리오바이러스에 의해 감염되는 소아마비, 노로바이러스와 지카바이러스, 환경파괴와 오염된 식수 등의 원인으로 발생하는 콜레라, 모기에게 물려 감염되는 뎅기열, 아프리카에서 시작된 엠폭스(원숭이두창)는 유럽과 아시아와 아메리카 등으로 확산했습니다.
누구나 다 알 수 있게 밖으로 드러난 다양한 병(病)은 피해가 발생해도 전 세계 정부와 관련 단체가 공동으로 신속하게 대응하게 됩니다. 그러나 기후변화로 인한 영구 동토층이 녹아내리면서 생각지도 못한 새로운 바이러스와 세균 등이 쏟아져 나온다면 그야말로 속수무책에 가까울 정도로 인류를 위협할 수 있습니다.

우리나라를 비롯한 전 세계 정부와 의료계 등은 신종 감염병 출현에 대응 준비에 분주합니다. 세계보건기구(WHO)는 감염병 세계적 대유행을 일으킬 수 있는 요주의 대상의 병원체 후보군 33가지를 발표했습니다. 세계보건기구가 지구촌을 공포로 몰고 갈 수 있을 것 같은 요주의 병원체를 지목한 것은 과거와 현재 인류를 엄습했거나 그럴 가능성이 있는 것들입니다.
특히 '미지의 질병X'와 예방접종을 하지 않아 면역력이 없는 천연두(시두)가 발생하면 감당하기 어렵습니다. 세계보건기구 사무총장은 "넥스트 팬데믹은 발생하느냐 않느냐의 문제가 아니라 언제 발생하느냐의 문제다."라고 했습니다. <생존의 비밀>은 '21세기는 전염병의 전성시대'라고 규정한 세계보건기구의 경고처럼 전염병 세계적 대유행의 시대를 사는 우리가 반드시 읽어야 할 필독서입니다.




약 20년 전 전 세계를 충격과 공포에 몰아넣은 사스가 발병했을 때 舊 질병관리본부 권준욱 방역과장(現 연세대 보건대학원 교수)은 "앞으로 훨씬 강력한 파괴력 가진 전염병이 닥쳐올 때 어떻게 대응해야 할지 고민이다."라고 했습니다. 사스 이후 2003~09년까지 조류독감, 2009년 신종플루 감염병 세계적 대유행, 2012~15년까지 메르스, 2019년 코로나19 세계적 대유행이 있었습니다.
인류 최초의 전염병이며 역사상 가장 많은 사상자가 발생한 전염병은 시두(천연두)지만, 단시간에 전 세계를 휩쓴 최악의 감염병은 스페인 독감 팬데믹이었습니다. 코로나19 전염병 세계적 대유행이 선언된 후 안토니우 구테흐스 유엔 사무총장은 "전 세계가 2차대전 이후 가장 큰 도전에 직면했다."라고 했지만, 진짜 거대한 위기는 이제부터 시작이라는 사실입니다.




《증산도 동방신선학교》 <생존의 비밀 1강>
병란(病亂)시대 진입의 신호탄 코로나19 감염병 팬데믹
머지않아 지구촌 전역을 휩쓸 전염병 세계적 대유행
https://www.youtube.com/watch?v=fcMFnoTFJdI

'증산도, 진리眞理' 카테고리의 다른 글
| 악업과 인과응보 극복하기 힘든 인간 내면의 마음에 생긴 상처 원한 (37) | 2025.01.08 |
|---|---|
| 병든 지구와 사회와 인간의 마음 다가오는 강력한 새로운 팬데믹 (45) | 2025.01.07 |
| 박고지금 과거는 현재를 비추는 거울이고 미래의 길을 제시하는 나침반이다 (40) | 2025.01.05 |
| 부산 금정산 해돋이 일출(日出)과 정상 고당봉 인근의 금빛 우물 금샘 (28) | 2024.12.29 |
| 2025년 을사년 진정한 새해 첫날 한 해의 소망을 담은 동짓날 동지등 (80) | 2024.11.30 |
| 세계 역사와 문화의 산실 증산도 상생월드센터 상량식 (46) | 2024.10.31 |
| 경상북도 청송군 주왕산 국립공원 주산지 가을단풍 추풍낙엽과 열매 (45) | 2024.09.29 |





댓글